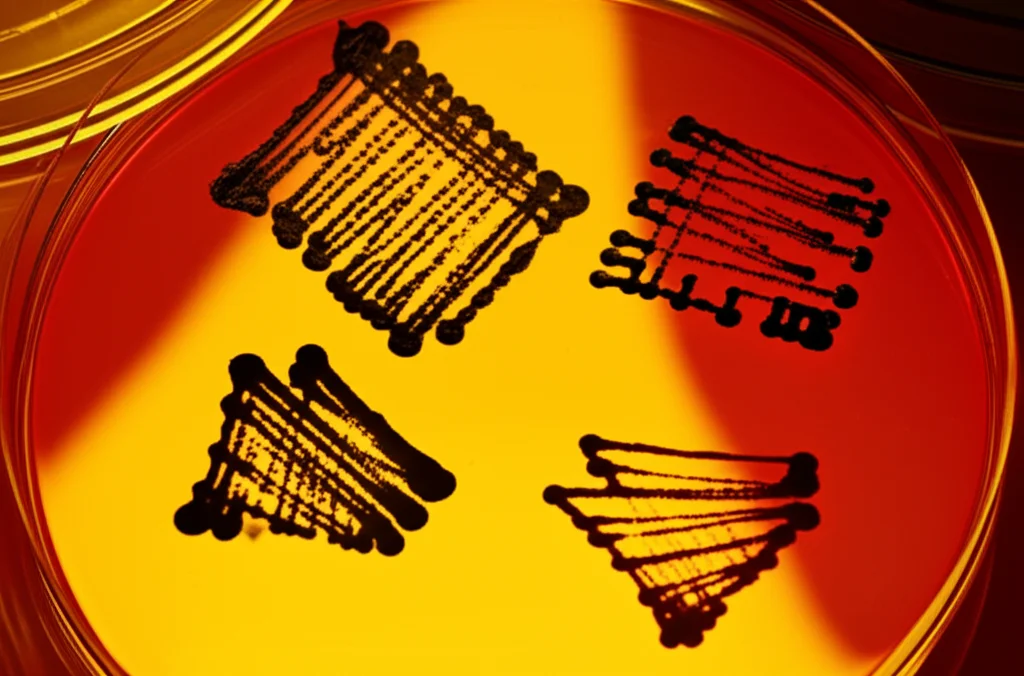
Macro fotografia di colonie batteriche di E. coli che crescono su una piastra di Petri in un incubatore da laboratorio, illuminazione controllata per evidenziare le differenze di crescita tra le colonie, lente macro 90mm, alta definizione, messa a fuoco precisa sulle diverse dimensioni delle colonie.

Batteri al Lavoro per la Nostra Salute: Vi presento LEICA, il Test Rivoluzionario!
Ciao a tutti! Oggi voglio parlarvi di qualcosa che mi entusiasma davvero tanto, un’idea che potrebbe sembrare uscita da un film di fantascienza, ma che invece è scienza pura e promette di fare grandi cose per la medicina. Immaginate di poter usare dei minuscoli operai, i batteri, per capire meglio le malattie genetiche umane e persino per trovare nuovi farmaci. Sembra pazzesco, vero? Eppure, è proprio quello che stiamo esplorando con un approccio che abbiamo chiamato LEICA (Live E. coli Assay).
Il Problema: Capire il nostro DNA
Partiamo da un fatto: il genoma umano, il nostro libretto di istruzioni biologico, non è uguale per tutti. Ognuno di noi ha delle piccole variazioni, delle “mutazioni”, rispetto a una sequenza di riferimento. Molte sono innocue, ma alcune possono causare problemi, portando a malattie ereditarie. Identificare queste varianti “colpevoli” è fondamentale, soprattutto ora che con tecniche come l’editing genetico si aprono nuove speranze di cura.
Il problema è che, anche se oggi grazie al sequenziamento high-throughput possiamo leggere il DNA a velocità incredibile e trovare tantissime variazioni, capire quali di queste siano davvero la causa di una malattia è un’altra storia. È una sfida enorme. I metodi tradizionali, come studiare le proteine isolate in provetta (in vitro), hanno i loro limiti: non sempre riflettono quello che succede davvero dentro una cellula viva, sono lenti e costosi. Gli studi su grandi popolazioni (GWAS) trovano associazioni statistiche, ma non provano un rapporto causa-effetto diretto. Insomma, avevamo bisogno di qualcosa di diverso.
L’Idea Geniale: “Umanizzare” i Batteri
Ed ecco che entra in gioco la nostra idea: usare un batterio comunissimo, l’Escherichia coli (sì, proprio lui!), come una sorta di “mini-laboratorio” vivente. Perché l’E. coli? Perché, nonostante l’enorme distanza evolutiva da noi umani, condivide con noi molti processi metabolici fondamentali, come la glicolisi (il modo in cui le cellule “bruciano” gli zuccheri per ottenere energia).
Cosa abbiamo fatto, quindi? Abbiamo preso dei batteri E. coli e abbiamo “spento” alcuni dei loro geni metabolici essenziali. Poi, al posto di questi geni batterici, abbiamo inserito i loro corrispondenti umani, gli ortologhi. In pratica, abbiamo creato degli E. coli “umanizzati” per specifiche funzioni.
La cosa fantastica è che la velocità di crescita di questi batteri modificati dipende direttamente da quanto bene funziona l’enzima umano che gli abbiamo dato! Se l’enzima umano è super efficiente, il batterio cresce velocemente. Se l’enzima umano ha una mutazione che lo rende meno attivo (come succede in alcune malattie genetiche), il batterio cresce più lentamente o non cresce affatto. Semplice e geniale, no?
Mettere alla Prova LEICA: GPI e G6PD
Per dimostrare che il nostro sistema funzionava, ci siamo concentrati su due enzimi umani le cui mutazioni sono cause note di malattie del sangue (enzimopatie ereditarie): la Glucosio-6-fosfato isomerasi (GPI) e la Glucosio-6-fosfato deidrogenasi (G6PD). La carenza di G6PD è diffusissima, colpisce milioni di persone nel mondo!
Abbiamo creato ceppi di E. coli “umanizzati” per GPI e G6PD, inserendo sia la versione normale (wild-type, WT) dell’enzima umano, sia diverse versioni con mutazioni note, alcune innocue (benigne) e altre che causano malattie (patogeniche). E i risultati? Strepitosi!
I batteri con le mutazioni patogeniche crescevano significativamente più piano rispetto a quelli con l’enzima normale. Quelli con mutazioni benigne crescevano quasi normalmente. Ma la cosa più importante è che abbiamo trovato una correlazione lineare altissima tra la velocità di crescita dei nostri batteri e l’attività enzimatica misurata in studi precedenti con metodi tradizionali (usando enzimi purificati). Bingo! LEICA funzionava e rifletteva accuratamente l’attività degli enzimi umani in vivo, o meglio, in un contesto cellulare vivo.
Questo apre la porta a uno screening rapidissimo ed economico delle tantissime varianti genetiche che scopriamo ogni giorno, per capire subito se possono essere dannose o meno. Addio a lunghi e costosi processi di purificazione!
Non Solo Mutazioni: LEICA per Scoprire Nuovi Farmaci
Ma le potenzialità di LEICA non finiscono qui. Ci siamo chiesti: potremmo usarlo anche per testare l’effetto di farmaci o altre molecole sugli enzimi umani?
Abbiamo fatto la prova con l’enzima G6PD. Esistono molecole che possono attivarlo (come un composto chiamato AG1) e altre che possono inibirlo. Abbiamo trattato i nostri batteri “umanizzati” per G6PD con queste sostanze. Risultato? LEICA ha risposto perfettamente!
Con l’attivatore AG1, i batteri (soprattutto quelli con una versione mutata di G6PD, la Canton) crescevano più velocemente. Con noti inibitori della G6PD (come G6PDi-1, DHEA, BMN), la crescita rallentava o si fermava, proprio come ci aspettavamo basandoci su studi precedenti. È interessante notare che le concentrazioni efficaci in LEICA erano più simili a quelle viste in test su cellule umane che a quelle dei test in vitro puri, suggerendo che il nostro sistema batterico mima meglio l’ambiente cellulare.
Presi dall’entusiasmo, abbiamo fatto un passo ulteriore: abbiamo usato LEICA per fare uno screening su una libreria di 160 composti noti per modulare il metabolismo umano. L’obiettivo era trovare nuove molecole che potessero influenzare la G6PD umana. Ebbene, abbiamo identificato 7 composti “hit” che inibivano la crescita dei batteri con G6PD umana ma non quella dei batteri di controllo (con G6PD batterica). La cosa incredibile è che tra questi 7, abbiamo “riscoperto” 3 composti già noti per interagire con la G6PD o per avere attività antimalarica (la G6PD è un bersaglio importante nella lotta alla malaria). Questo ci ha dato grande fiducia nella sensibilità e affidabilità di LEICA come strumento di drug discovery! Gli altri 4 composti identificati sono ora candidati interessanti da studiare ulteriormente.

Oltre la Glicolisi: LEICA è Versatile
Per dimostrare che LEICA non è limitato agli enzimi della glicolisi, abbiamo tentato l’esperimento con un altro enzima, l’Argininosuccinato liasi (ASL). Questo enzima fa parte del ciclo dell’urea negli umani, un processo che l’E. coli non ha, ma possiede un enzima simile (codificato dal gene argH) per produrre l’aminoacido arginina.
Abbiamo creato un E. coli senza il suo gene argH (rendendolo incapace di produrre arginina e quindi di crescere senza di essa) e gli abbiamo fornito l’ASL umano. Anche in questo caso, l’ASL umano ha funzionato e ha permesso al batterio di crescere! Poi abbiamo testato diverse varianti mutate di ASL che causano una malattia genetica chiamata aciduria argininosuccinica. Ancora una volta, i batteri con le versioni mutate e meno attive dell’enzima crescevano molto più lentamente, in linea con la gravità della malattia associata a quella specifica mutazione. Questo dimostra che LEICA è una piattaforma flessibile, applicabile a diversi tipi di enzimi e vie metaboliche.
Un Ponte tra i Mondi e Uno Sguardo al Futuro
Quindi, cosa abbiamo tra le mani con LEICA? Abbiamo un sistema che si colloca a metà strada tra i test in vitro classici e i test su cellule umane. È più semplice, veloce ed economico dei metodi tradizionali, ma cattura parte della complessità dell’ambiente cellulare che manca ai test in provetta.
Certo, ha delle limitazioni. Non possiamo usarlo per testare composti che sono tossici per i batteri stessi (antibiotici, per esempio), perché otterremmo falsi positivi. E la permeabilità delle membrane batteriche ai farmaci potrebbe essere diversa da quella delle cellule umane. Ma facendo i controlli giusti (comparando sempre con batteri non “umanizzati”), possiamo superare molti di questi ostacoli.
Le prospettive sono davvero entusiasmanti. LEICA potrebbe accelerare enormemente:
- L’identificazione delle mutazioni che causano malattie genetiche.
- Lo screening di migliaia di composti per trovare nuovi farmaci.
- Lo sviluppo della medicina personalizzata, magari testando rapidamente quale farmaco funziona meglio per un paziente con una specifica mutazione enzimatica.
Insomma, stiamo sfruttando la potenza dei batteri, macchine biologiche incredibilmente versatili, per far luce sui meccanismi delle malattie umane e trovare nuove soluzioni terapeutiche. È un campo di ricerca in pieno fermento e credo che sentiremo parlare ancora molto di approcci come LEICA nel prossimo futuro. Non è affascinante?
Fonte: Springer Nature
